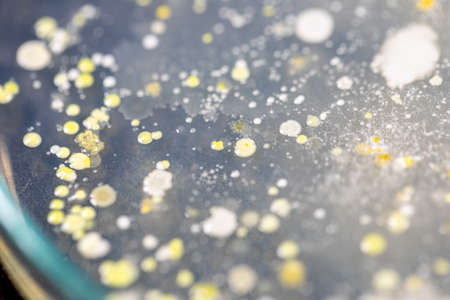
Backgrounds of Characteristics and Different shaped Colony of Bacteria and Mold growing on agar plates from Soil samples for education in Microbiology laboratory.の写真素材

写真素材 - Backgrounds of Characteristics and Different shaped Colony of Bacteria and Mold growing on agar plates from Soil samples for education in Microbiology laboratory.
作品情報
Backgrounds of Characteristics and Different shaped Colony of Bacteria and Mold growing on agar plates from Soil samples for education in Microbiology laboratory.
- ID:186409355
- 作品種別:写真
- 作者名:sinhyu
キーワード
- actinomyces
- agar
- analysis
- background
- bacteria
- bacterial
- bacterium
- biology
- biotechnology
- characteristic
- colony
- danger
- disease
- education
- environment
- equipment
- experiment
- food
- fungi
- germs
- growing
- growth
- health
- health care
- hygiene
- identification
- isolated
- lab
- laboratory
- medical
- medicine
- micro
- microbial
- microbiology
- microorganism
- mold
- molds
- pattern
- petri
- plate
- research
- risk
- safety
- sample
- samples
- science
- shape
- soil samples
- species
- yeast
類似作品
Abstract backgr...
Geometric shape...
Wooden colorful...
paper bookmarks...
Abstract colore...
Complementary c...
Abstract organi...
top view geomet...
Abstract white ...
Abstract color ...
Layout composit...
Texture backgro...
Multi colored a...
different paper...
Overlapped colo...
A round ring po...
White geometric...
Layout composit...
Abstract compos...
Retro style pho...
abstract geomet...
Multi-colored a...
Abstract paper ...
Chaotic curved ...
Texture backgro...
abstract backgr...
Abstract backgr...
Multi-colored s...
Abstract geomet...
Toys banner bac...
Banner and pano...
Overlapped colo...
abstract color ...
Old tree struct...
Craft, material...
White podiums g...
beautiful backg...
Abstract compos...
Colored triangl...
Bright Abstract...
Studing concept...
Abstract backgr...
White and orang...
Origami gamepad...
Metaverse, futu...
Abstract geomet...
greeting card m...
colorful wood p...
Ranunculus (cro...